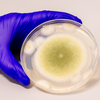

Ahli Ungkap Cara Atasi Munculnya Jamur dan Lumut di Rumah Saat Musim Hujan

KOMPAS.com - Musim hujan mulai datang, udara di dalam dan sekitar rumah pun menjadi lebih lembap.
Jika atap atau dinding mengalami kebocoran dan rembes, kondisi tersebut semakin membuka peluang tumbuhnya jamur dan lumut.
Dari bercak hitam berlendir di tirai kamar mandi, noda putih berbulu di lantai bawah, hingga lapisan oranye licin yang muncul di saluran pembuangan dapur, keberadaan jamur di rumah memang bikin resah.
Lebih buruknya lagi, jamur bisa memicu gangguan kesehatan, terutama bagi mereka yang memiliki alergi atau asma.
Namun, meski Anda tidak memiliki alergi, paparan jamur tetap berpotensi mengiritasi mata, kulit, hidung, tenggorokan, hingga paru-paru.
Karena itu, penting untuk mengetahui cara mengatasinya agar rumah tetap sehat dan nyaman dihuni.
Berikut panduan mencegah dan membersihkan jamur agar kondisi hunian dan kesehatan keluarga tetap terjaga.
Baca juga: Benarkah Noda Coklat pada Keripik Kentang adalah Jamur? ini Kata Pakar UGM
Cara mengatasi jamur dan lumut yang tumbuh di rumah
Para pakar membagikan sejumlah tips untuk membantu membersihkan jamur yang membandel di dalam rumah.
Jamur merupakan jenis mikroorganisme mirip cendawan yang tumbuh pada area lembap seperti dinding, jendela, hingga sudut-sudut ruangan.
pertumbuhan jamur dan lumut akibat kadar kelembapan tinggi, permukaan basah, dan penumpukan kondensasi.
Dalam banyak kasus, masalah kecil seperti kelembapan dan jamur sebenarnya bermula dari satu pemicu utama: kondensasi.
“Jamur dapat muncul dalam berbagai bentuk, namun umumnya terlihat sebagai bintik-bintik gelap atau berkumpul di beberapa titik di rumah,” ujar Edward Jonkler dari Remora Cleaning di London, Inggris, dikutip dari Independent, Selasa (28/5/2025).
Ia mengingatkan bahwa jamur bisa terus muncul dan menyebar jika dibiarkan begitu saja, tanpa upaya pembersihan rutin dan perbaikan kondisi rumah yang memicu kelembapan.
Berikut cara mencegah pertumbuhannya:
Baca juga: BRIN Temukan Spesies Jamur Baru di Gunung Rinjani, Seperti Apa Bentuknya?
1. Jamur di kamar mandi
Jamur hitam yang muncul di area kamar mandi memang bikin tak nyaman.
-
 Temuan "Jamur Kutukan Firaun" yang Disebut Bisa Lawan Kanker
Temuan "Jamur Kutukan Firaun" yang Disebut Bisa Lawan Kanker -
 Benarkah Keputihan dan Infeksi Jamur di Area Selangkangan Bisa Picu Kanker Serviks?
Benarkah Keputihan dan Infeksi Jamur di Area Selangkangan Bisa Picu Kanker Serviks? -
 Cerita Ilmuwan Temukan Jamur di Hutan Amazon yang Bisa Makan Sampah Plastik
Cerita Ilmuwan Temukan Jamur di Hutan Amazon yang Bisa Makan Sampah Plastik -
 BRIN Temukan Spesies Jamur Baru di Gunung Rinjani, Seperti Apa Bentuknya?
BRIN Temukan Spesies Jamur Baru di Gunung Rinjani, Seperti Apa Bentuknya? -
 Benarkah Noda Coklat pada Keripik Kentang adalah Jamur? ini Kata Pakar UGM
Benarkah Noda Coklat pada Keripik Kentang adalah Jamur? ini Kata Pakar UGM